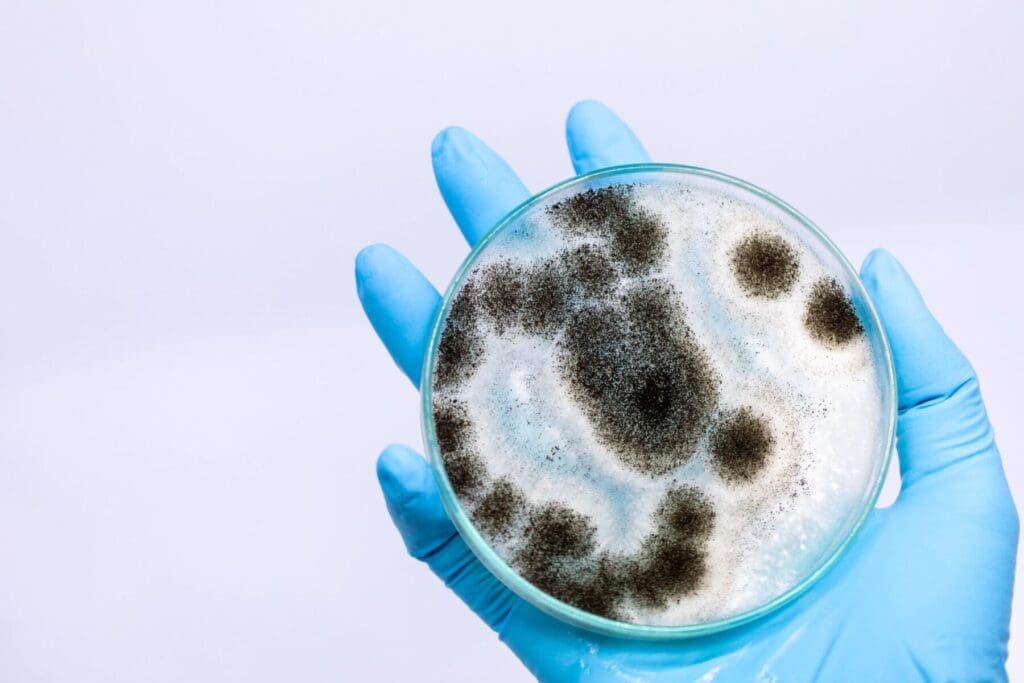
Mold FAQ spores water damage remediation

FAQs About Mold Damage & Removal
Why do you need to build a containment for mold removal?
The most important thing in mold remediation is to control the air flow. Mold spores travel through the air and they get moved or dispersed very easily. Just walking past an area that has mold growing on it can spread those spores throughout your house. Any growth that is over 10 square feet should be contained or covered in plastic as soon as possible to minimize the risk of it spreading. That’s why building a containment for mold removal is so important because when we are removing the mold, cutting the building materials out that have mold on them we will be disturbing the mold and that causes the mold spores to go airborne.
It’s very easy for your HVAC system to pick up those spores and spread them throughout your house or building. After we set up a containment, we can control the air flow. This allows us to direct the spores to a specific location. Building a containment is the first critical step in performing mold remediation.
If the mold is everywhere in the house do I still need a containment?
In situations where mold is present in every room of the house, containment measures are typically not necessary as the entire house essentially becomes the containment area. This means that every room will need to be thoroughly cleaned to remove the mold.
Additionally, air scrubbers will be used to help purify the air and remove any mold spores that may be circulating throughout the house. This wholistic approach ensures that all areas of the house are addressed and that the mold problem is effectively remediated.
Can I just clean the mold with bleach?
There are many chemicals that will kill mold, including bleach. The problem with that plan is using bleach on the mold only kills the mold, but doesn’t remove it from the living area. Normally dead mold spores are just as harmful as spores that are alive so just killing the mold is not a complete remediation plan.
The proper way to do mold remediation is to REMOVE the mold from the environment. This is done by using Air Filtration Devises or “air scrubbers” that have HEPA filters in them and process large amounts of air through those air scrubbers to capture the mold spores, then physically removing all the visible mold growth that you can find, then doing a highly detailed HEPA vacuuming and wet wiping every surface in the effected area.
Following this process will help to actually remove the mold from the area and not just spraying some chemical on the mold that will just kill it.
My AC guy said he can install a UV light to kill all the mold, will that work?
UV light has been proven to effectively kill mold spores when they are exposed to the light for a sufficient amount of time. However, it is important to note that while UV light can eliminate mold spores, it does not actually remove them from the affected area. This means that even though the mold spores may be dead, they can still remain in the environment and potentially cause health issues if not properly removed.
In order to completely eradicate a mold problem, it is essential to not only kill the spores but also physically remove them from the area. This can involve thorough cleaning, scrubbing, and disinfecting of the affected surfaces to ensure that all traces of mold are eliminated. Additionally, it is important to address any underlying moisture issues that may be contributing to the mold growth in order to prevent future outbreaks.
While UV light can be a useful tool in the fight against mold, it should be used in conjunction with other remediation methods to ensure a comprehensive approach to mold removal. By combining UV light treatment with proper cleaning and moisture control measures, you can effectively eliminate mold from your home and create a healthier living environment for you and your family.
How much does mold removal cost?
The cost will vary greatly depending on how extensive the mold has spread. The problem with mold is that the spores are too small to see with the naked eye unless you see their colonies growing. So in effect, there could be mold spores that have spread into other parts of your house by your HVAC system and you are not able to see them.
Mold removal costs can vary depending on the extent of the infestation and the type of mold present. When you can see mold growing in colonies on surfaces, the cost to remove it may be relatively low. This typically involves cleaning and treating the affected areas to eliminate the visible mold.
However, the real challenge lies in removing the unseen mold spores that have been distributed throughout the rest of the home. These spores can be present in the air and on surfaces, making it difficult to completely eradicate them. This often requires more extensive remediation efforts, such as thorough cleaning, disinfection, and possibly even the use of specialized equipment like air scrubbers.
The cost of removing these unseen mold spores can be quite expensive, as it may involve more time, labor, and resources to ensure that the mold is completely eliminated. It is important to address mold issues promptly and thoroughly to prevent further spread and potential health risks associated with mold exposure.
How do you make sure the mold doesn’t spread?
The best way to make sure mold doesn’t spread throughout the house is to contain the visible growth that you can see and control the airflow as best you can. You can contain the visible mold by getting a trash bag or piece of plastic and cutting it to size to cover the visible mold. Use good duct tape to tape that plastic over the affected area. You can also contain whole rooms by shutting off the HVAC supply / return registers to those affected areas until you can get a professional to do an inspection. I would not recommend turning off your HVAC system, especially since we are in Florida and most of the year the humidity outside is over 60%.
How do you know how far the mold spread throughout the house?
The best way to know how far the mold has spread is to have an industrial hygienist perform air testing in different areas of your house. It’’s fairly easy to see the visible mold growing in colonies, but the spores that have possibly spread throughout the house are too small to be seen and can only be detected through an air sample.
The Industrial Hygienist has a machine that will direct air through a small cassette or container that traps whats in the air. That sample is sent to a lab to be analyzed. The report will show what kind of mold is found to be in the air and in what quantity. Using that information you can get a picture of how far the mold has spread in the house and in what quantity. He can also do a tape sample. That process is just like it sounds. He takes tape and presses it to surface, and that is sent to a lab and is analyzed and a report is given to show what kind and what quantify is on that tape sample.




